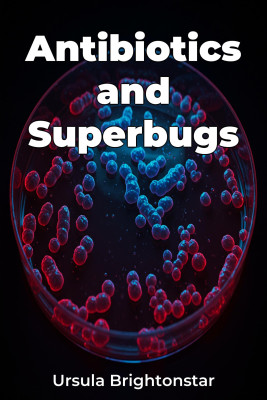

Superbug Evolution by Ursula Brightonstar

Synopsis
Superbug Evolution explores the escalating crisis of antimicrobial resistance, focusing on multidrug-resistant organisms and their impact on global healthcare. It examines the evolutionary mechanisms driving antibiotic resistance, revealing how widespread antibiotic use in medicine and agriculture inadvertently fosters the development of superbugs. The book highlights that superbug emergence is not just a medical issue but a complex ecological and evolutionary challenge shaped by human actions.
The book begins with a historical overview of antibiotic use and the subsequent rise of resistance. It then progresses to detail the genetic mechanisms bacteria use to evade antimicrobials and analyzes the ecological factors influencing superbug spread in various environments. Later chapters address clinical implications, offering strategies for infection control and advocating for a One Health approach, recognizing the interconnectedness of human, animal, and environmental health.
This book uniquely integrates evolutionary principles into the analysis of antimicrobial resistance, moving beyond a purely medical perspective. Drawing from scientific literature and epidemiological data, it presents a thorough exploration of this pressing global health issue, making complex concepts accessible to a broad audience. It emphasizes the need for interdisciplinary collaboration to combat this threat.
Reviews
Write your review
Wanna review this e-book? Please Sign in to start your review.